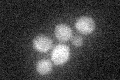
YER127W
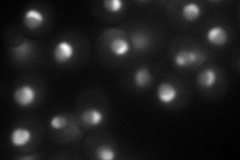
YER127W
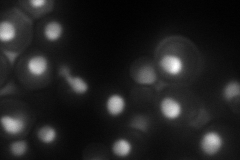
YER127W

View description
Essential protein involved in maturation of 18S rRNA; depletion leads to inhibited pre-rRNA processing and reduced polysome levels; localizes primarily to the nucleolus
Localization:
Intensity:
Fold change:
Significance:
-
C’ GFP library in SD
below threshold17.08 -
N' NOP1pr-GFP in SD
nucleolus91.1699 -
N' TEF2pr-mCherry in SD
nucleus,nucleolus93.3707 -
N' NATIVEpr-GFP in SD

nucleolus59.4596 -
N' TEF2pr-VC and Cyto-VN in SD

#N/A0 -
C’ GFP library in SD+DTT

cytosol14.410.84No -
C’ GFP library in SD+H2O2

cytosol19.471.13No -
C’ GFP library in Starvation Media

cytosol23.911.39No -
C’ GFP library on the background of Pup2-DaMP

below threshold -
C’ GFP library on the background of CCT mutant

below threshold18.39851.07674No
